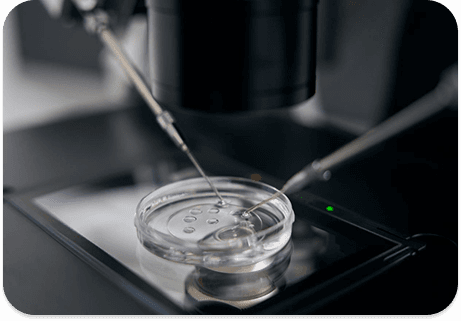
Egg Donation

Our Services
We offer a comprehensive range of fertility treatments and diagnostic services.
Egg Freezing
A modern fertility preservation method that allows women to store their healthy eggs at a younger age for future use. Ideal for those delaying pregnancy due to career, medical treatments, or personal choice, it offers the freedom to plan parenthood on your own timeline. At HomeIVF, we make egg freezing simple and stress-free, offering expert consultation, hormone monitoring, egg retrieval coordination, and lab support.

What
is Egg Freezing?
Egg freezing, medically known as oocyte cryopreservation, is a process where a woman's eggs are extracted, frozen, and stored for future use. These eggs can later be thawed, fertilized with sperm, and implanted through IVF to help achieve pregnancy.
Egg Freezing Specialists

Our Doctors
Have Questions? Learn More

Frozen Embryo Transfer→
Learn about the process of preserving and transferring frozen embryos for future pregnancy attempts.

Ovarian Egg Reserve→
Understanding your ovarian reserve and how it impacts fertility treatment options and success rates.
Egg Donation→
Comprehensive guide to egg donation procedures, recipient preparation, and emotional considerations involved.
Explore
Other Services
Genetic Compatibility
Assesses genetics of parents to identify potential hereditary risks for offspring.
Egg Freezing
Preserves a woman's eggs for future use, allowing flexibility in family planning.
Conception Support
Provides comprehensive care for reproductive health and fertility concerns.